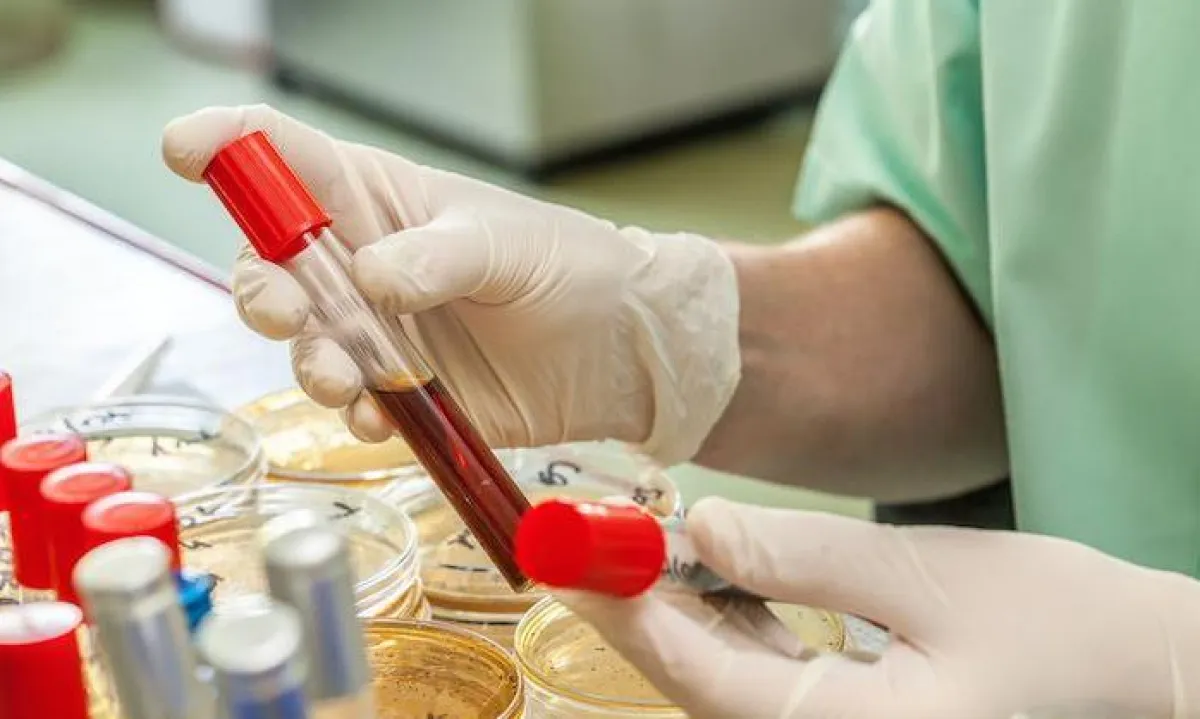

اختبار جديد سيبصر النور قريباً يساعدك على معرفة تاريخ ولادة طفلك، ويكشف عن الولادة المبكرة بنسبة نجاح تصل إلى 80 بالمائة.
سوف يكشف فحص جديد للدم وغير مكلف ما إذا كانت المرأة الحامل سوف تواجه ولادة مبكرة لطفلها، وذلك حسب نتائج دراسة نشرت في مجلة العلوم الطبية Medical Science . وأعلن العلماء أنّ الاختبار سيكون فعالاً في تقليل أعداد الوفيات، والمضاعفات التي تلي حوالي 15 مليون ولادة مبكرة في شتى أرجاء العالم. وتصل نسبة الولادات المبكرة إلى حوالي 9 في المائة في الولايات المتحدة على سبيل المثال، وهي السبب الرئيسي للوفيات بين الأطفال قبل سن 5 سنوات في شتى أنحاء العالم.

اختبار في متناول الجميع
توصل باحثون أمريكيون ودنماركيون إلى اختبار بمقدوره أن يعطي نتائج صحيحة بنسبة 80 في المائة حول ما إذا كانت المرأة الحامل سوف تلد طفلها ولادة مبكرة. ويقوم الجهاز بتحليل نشاط جينات الأمومة والمشيمة والجنين، ويقيّم مستويات الحمض النووي الريبوزي الخالي من الخلايا (الجزيئات الناقلة التي تنقل التعليمات الوراثية للجسم) . ويحدّد الاختبار كذلك تاريخ الولادة بشكل موثوق، وتكلفته رخيصة مثل فحص الألتراساوند (فحص الموجات فوق الصوتية).
"لقد وجدنا أن هناك حفنة من العوامل الوراثية بمقدورها أن تتنبأ ما إذا كانت المرأة معرضة إلى خطر وضع مولودها قبل الأوان"، أعلن مادس ميلبي، المؤلف الرئيسي المشارك للدراسة والبروفسور الزائر لدى جامعة ستانفورد، والمدير الإداري لمعهد الأمصال في كوبنهاغن.
وأضاف: "لقد أمضيت الكثير من السنوات وأنا أعمل لفهم الولادة المبكرة، وهذا الاختبار أول تقدم علمي حقيقي ومهم بشأن هذه المشكلة منذ فترة طويلة".
وإذا كانت نتائج هذه الدراسة مشجعة ، فهناك حاجة إلى مزيد من الأبحاث قبل استخدامها على نطاق واسع.

Google News
Google News 

















